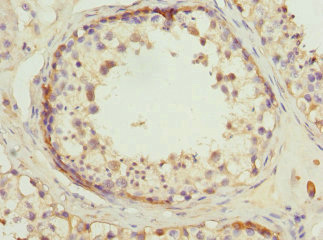

RDH5 Antibody
-
中文名稱:RDH5兔多克隆抗體
-
貨號:CSB-PA856423ESR1HU
-
規格:¥440
-
圖片:
-
其他:
產品詳情
-
產品名稱:Rabbit anti-Homo sapiens (Human) RDH5 Polyclonal antibody
-
Uniprot No.:
-
基因名:RDH5
-
別名:RDH5 antibody; HSD17B9 antibody; RDH1 antibody; SDR9C5 antibody; Retinol dehydrogenase 5 antibody; EC 1.1.1.209 antibody; EC 1.1.1.315 antibody; EC 1.1.1.53 antibody; 11-cis retinol dehydrogenase antibody; 11-cis RDH antibody; 11-cis RoDH antibody; 9-cis retinol dehydrogenase antibody; 9cRDH antibody; Short chain dehydrogenase/reductase family 9C member 5 antibody
-
宿主:Rabbit
-
反應種屬:Human
-
免疫原:Recombinant Human 11-cis retinol dehydrogenase protein (24-318AA)
-
免疫原種屬:Homo sapiens (Human)
-
標記方式:Non-conjugated
-
克隆類型:Polyclonal
-
抗體亞型:IgG
-
純化方式:Antigen Affinity Purified
-
濃度:It differs from different batches. Please contact us to confirm it.
-
保存緩沖液:PBS with 0.02% sodium azide, 50% glycerol, pH7.3.
-
產品提供形式:Liquid
-
應用范圍:ELISA, IHC
-
推薦稀釋比:
Application Recommended Dilution IHC 1:20-1:200 -
Protocols:
-
儲存條件:Upon receipt, store at -20°C or -80°C. Avoid repeated freeze.
-
貨期:Basically, we can dispatch the products out in 1-3 working days after receiving your orders. Delivery time maybe differs from different purchasing way or location, please kindly consult your local distributors for specific delivery time.
-
用途:For Research Use Only. Not for use in diagnostic or therapeutic procedures.
相關產品
靶點詳情
-
功能:Catalyzes the oxidation of cis-isomers of retinol, including 11-cis-, 9-cis-, and 13-cis-retinol in an NAD-dependent manner. Has no activity towards all-trans retinal. Plays a significant role in 11-cis retinol oxidation in the retinal pigment epithelium cells (RPE). Also recognizes steroids (androsterone, androstanediol) as its substrates.
-
基因功能參考文獻:
- a novel homozygous missense mutation, (c.602 C > T) in exon 4 of the RDH5 gene (MIM: 601617) was identified. This mutation resulted in substitution of phenyl alanine for serine at amino acid 201 (p.Ser201Phe) of the RDH5 gene. Identification of this mutation reveals the allelic heterogeneity of RDH5 in patients with retinitis pigmentosa phenotype. PMID: 29892959
- We conclude that the expression of Rlbp1 and Rdh5 critically depends on functional Mitf in the RPE and suggest that MITF has an important role in controlling retinoid processing in the RPE. PMID: 26876013
- A novel c.832C>T (p.Arg278Ter) nonsense mutation in RDH5 was identified. Preserved rod function was observed in one young subject in this study. PMID: 25170858
- Macular cone density is lower and the regularity of the macular cone mosaic spatial arrangement is disrupted in eyes with fundus albipunctatus. PMID: 24246574
- RDH5 sequence analysis revealed a novel five base pair deletion, c.913_917delGTGCT (p.Val305Hisfs*29), in family A, and a novel missense mutation, c.758T>G (p.Met253Arg), in family B with fundus albipunctatus. PMID: 22736946
- Four novel RDH5 gene mutations were identified in fundus albipunctatus Israeli patients. Of them, the null mutations c.343C>T (p.R54X) and c. 242delTGCC were the most prevalent. PMID: 22815624
- The proband had a compound heterozygotic missense mutation of Cys59Ser (TGC --> AGC) and a nonsense mutation of Trp95ter (TGG --> TGA) in the RDH5 gene. PMID: 22669287
- The clinical and electrophysiologic phenotype of patients with RDH5 retinopathy is variable. PMID: 21529959
- Mutations in RDH5 associated with fundus albipunctatus seem to prevent normal lipofuscin accumulation. PMID: 20829743
- An amino acid important for steroid/retinoid discrimination was identified and its significance was highlighted by the results of molecular modeling studies. PMID: 20382160
- Macular dystrophy is caused by the RDH5 mutation as a phenotype variation in fundus albipunctus. PMID: 11812441
- Macular dystrophy is caused by the RDH5 gene mutation as a phenotype variation in fundus albipunctatus. PMID: 12788147
- Fundus changes due to Fundus albipunctatus associated with mutations in the RDH5 gene. PMID: 12860821
- RDH5 gene mutations cause a progressive cone dystrophy or macular dystrophy as well as night blindness. The clinical phenotype including electrophysiological responses varied among patients with the RDH5 gene mutations. PMID: 12906118
- A homozygous G490T (Val164Phe) missense RDH5 gene mutation was detected. PMID: 12967826
- Homozygous Gly107Arg mutation in the RDH5 gene in two unrelated Japanese families with fundus albipunctatus. PMID: 15007239
- Cone dystrophy can be present in patients with fundus albipunctatus, not only elderly men but also young women. PMID: 15302662
- Our study indicates that different mutations in the RDH5 gene can cause phenotypic variations of either fundus albipunctatus or familial fleck retina with night blindness. PMID: 16637847
- study describes an unusual family which included a mother with fundus albipunctatus and three children with typical retinitis pigmentosa; a novel RDH5 mutation was found PMID: 18363170
顯示更多
收起更多
-
相關疾病:Fundus albipunctatus (FALBI)
-
亞細胞定位:Endoplasmic reticulum membrane; Multi-pass membrane protein; Lumenal side.
-
蛋白家族:Short-chain dehydrogenases/reductases (SDR) family
-
組織特異性:Widely expressed. In the eye, abundant in the retinal pigment epithelium.
-
數據庫鏈接:
Most popular with customers
-
YWHAB Recombinant Monoclonal Antibody
Applications: ELISA, WB, IHC, IF, FC
Species Reactivity: Human, Mouse, Rat
-
Phospho-YAP1 (S127) Recombinant Monoclonal Antibody
Applications: ELISA, WB, IHC
Species Reactivity: Human
-
-
-
-
-
-